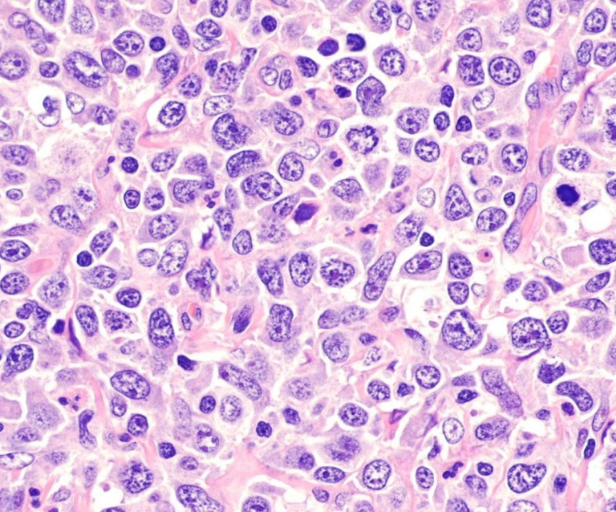
Breakthrough gives hope in fight against aggressive form of blood cancer

News
Keep up to date with the latest medical innovation news at the University of Southampton.
-

Southampton researchers react to new National Cancer Plan
Southampton academics who helped shape the UK government’s 10-year National Cancer Plan…
-

Researchers trial rapid test for winter respiratory infections
Southampton researchers are trialling a new test that could cut the time…
-

Researchers find promising new way to boost the immune response to cancer
Researchers at the University of Southampton have developed a promising new way…
-

Adding antibody treatment to chemo boosts outcomes for children with rare cancer
Children with a rare form of cancer called neuroblastoma which hasn’t responded…
-

New vaccine offers fresh hope for controlling whooping cough
A human challenge trial has shown a new vaccine could offer better…
-

Scientists discover how E. coli beats antibiotics in the gut
Toxic bug E. coli uses a secret weapon to survive in our…
-

New collection of bacteria-eating viruses to tackle hospital superbug
Potential treatments for one of the world’s most dangerous hospital superbugs have…
-

New study to explore whether weight loss drugs could boost breast cancer treatment for women with obesity
Researchers at the University of Southampton will investigate whether weight loss and…
-
Breakthrough gives hope in fight against aggressive form of blood cancer
A human challenge trial has shown a new vaccine could offer better…
-

Analysing exercise, diet and body composition may improve breast cancer treatment
A team of cancer scientists and clinicians at the University of Southampton…
-

Southampton-led team to develop next-gen cancer treatments
A consortium led by the University of Southampton has received funding to…
-

New insights could help phages defeat antibiotic resistant bacteria
Researchers at the University of Southampton have worked out how bacteria defend…